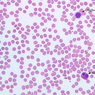
A100, Blood Smear, 40x Labeled (Wright)
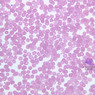
A100, Blood Smear, 40x (Wright)
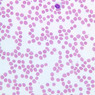
A100, Blood Smear, 40x (Wright)
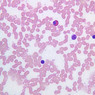
A100, Blood Smear, 40x (Wright)
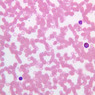
A100, Blood Smear, 40x (Wright)
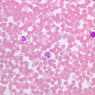
A100, Blood Smear, 40x (Wright)
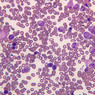
A5, Bone Marrow, 40x (Wright)
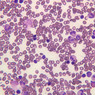
A5, Bone Marrow, 40x (Wright)
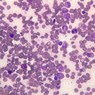
A5, Bone Marrow, 40x (Wright)
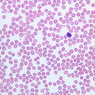
blood
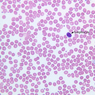
blood
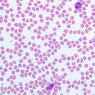
blood
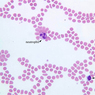
blood
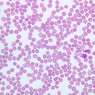
blood
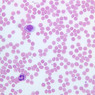
blood
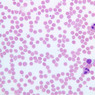
blood
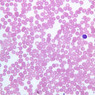
blood
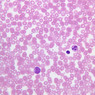
blood
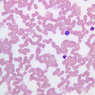
blood
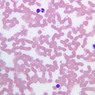
blood
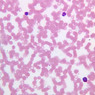
blood
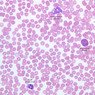
blood
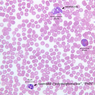
blood
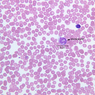
blood
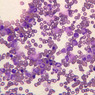
blood

You are here: Medical Histology>Main Web>AtlasContents>BloodAndBoneMarrowAtlas10 (20 Jun 2015, LorenEvey)Edit Attach
Chapter Ten: Peripheral Blood and Bone Marrow
Introduction
Blood is one of the primary means by which various parts of the body are kept in constant communication. It contains information-bearing molecules such as hormones and antibodies, as well as the various molecules of foodstuffs necessary for bodily nutrition. The molecular contents and the fluid portion of blood cannot be adequately studied with the microscope, and therefore, microscopy deals primarily with the cellular elements of blood "tissue." The cells serve as efficient carriers of oxygen to support metabolism in all tissues of the body and as protectors against injury and foreign invasions of the body. Studies of the cells in stained blood smears will quickly distinguish between the oxygen-bearing, anucleated erythrocytes and the basophilic, nucleated leukocytes, which perform diverse roles of bodily defense. Recognition of the cell types and the frequency of their occurrence and relating these factors to states of bodily function is one of the major diagnostic tools of medicine. Blood is a modified connective tissue. The ground substance is a fluid called blood plasma. The fibers form only during clotting and are called fibrin. The cellular elements are free floating in blood. They are divided into two types: erythrocytes (red blood cells) and leukocytes (white blood cells). Blood cells, like other connective tissue cells, originate from the mesoderm in the developing embryo. In the adult, they arise from reticular connective tissues of blood forming organs (red bone marrow).Top of page
Blood Cells
Study a blood smear stained with Wright's stain (slide A-100 [40x, 40x, 40x-labeled, 40x-labeled, 40x, 40x-labeled, 40x-labeled, 40x, 40x, 40x, 40x-labeled, 40x, 40x, 40x-labeled, 40x-labeled, 40x, 40x, 40x, 40x, 40x, 40x, 40x, 40x, 40x, 40x, 40x, 40x, 40x]). Blood cells and fragments in the smear will be of four principal types: erythrocytes, granular leukocytes, agranular leukocytes, and blood platelets.Erythrocytes
Erythrocytes (red blood cells, RBCs) appear orange to greenish-tan in color and are 7-8 microns in diameter (A-100 [40x-labeled]). The central lighter area of each cell reflects its biconcave shape and does not represent a nucleus. No structure can be seen in the cell. Note the frequency of RBCs with respect to the leukocytes, which all have basophilic nuclei. An occasional RBC may appear with a pyknotic nucleus; such a form is a normoblast and represents the last nucleated developmental stage of the red cell prematurely released from the bone marrow. There are about 4-5 million RBCs per cubic millimeter of blood. This number will differ slightly depending on the sex of individual. Occasionally, you will find RBCs stacked like poker chips called rouleaux. This is common in blood diseases where there are too many RBCs or immunoglobins. Is the shape of the RBC important for it to function properly?Top of page
Leukocytes
Leukocytes (WBCs) number only 6,000 to 9,000 per cubic mm. There are two groups of leukocytes classified according to the presence or absence of obvious granules in the cytoplasm. (1) granular leukocytes consist of neutrophils, eosinophils, and basophils; (2) agranular leukocytes are comprised of lymphocytes and monocytes.Granular Leukocytes
Neutrophils
Also called neutrophilic polymorphonuclear leukocytes ("PMN"), they are the most prominent type of granular leukocyte (55-60%). It has a deeply basophilic lobulated nucleus, usually consisting of 3-5 lobes (A-100 [40x-labeled, 40x-labeled, 40x-labeled]). Sex chromatin in female cells may appear as a separate small lobe of the nucleus called a drumstick. Immature circulating neutrophils with a horseshoe-shaped nucleus are occasionally seen; these are called band neutrophil. The cytoplasm of the neutrophil is lightly acidophilic and contains fine, pink-staining granules. The mature cells range in size from 10 to 15μ in diameter. Neutrophils act as bacterial phagocytes. In the EM, two types of granules are recognized; specific granules and azurophilic granules.Eosinophils
These are less frequently observed. These comprise 2-5% of the total leukocyte count. This cell is also characterized by a deeply basophilic nucleus, but with only 2-3 lobes. Coarse orange-to-red granules fill much of the cytoplasm, which measures 10-15μ diameter (A-100 [40x-labeled, 40x]). Eosinophils are active in the phagocytosis of molecular antigen-antibody complexes and thus their granules also represent lysosomes. The fine structure of neutrophilic and eosinophilic granules differs, however, suggesting different activities and contents of the lysosomes. The eosinophilic granules typically contain crystalline cores of a dense material not present in neutrophilic granules.Basophils
These are the least frequent granular leukocyte (~1%), consequently they are difficult to find. This cell is principally recognized by its mass of coarse metachromatic (in this case, purple or dark blue) granules (A-100 [40x, 40x]). The nucleus, with 2-3 lobes is usually obscured by the granules. Basophils range to about the same size as the other granulocytes. The metachromatic granules resemble those of tissue mast cells and have a similar content of heparin and histamine. The cells are minimally phagocytic and the granules therefore are probably not lysosomes.Top of page
Agranular Leukocytes
Lymphocytes
These are the most numerous type of agranulocyte and make up 30- 35% of the total leukocyte population. Most of the lymphocytes in the blood (90%) are classified as small lymphocytes (A-100 [40x-labeled, 40x-labeled]). These are 7.5μm in diameter and with a very thin rim of bluish cytoplasm surrounding the nucleus. The nucleus is round or slightly indented, contains a rather granular chromatin, and fills most of the cell. The large lymphocyte (up to 12 in diameter) has considerably more bluish staining cytoplasm (A-100 [40x-labeled, 40x-labeled]; small red purple granules may be present). In EM's, these cells have granular cytoplasm with many ribosomes.Monocytes
These may be confused morphologically with large lymphocytes, but they act quite differently within loose connective tissues (A-100 [40x-labeled, 40x-labeled, 40x-labeled]). Monocytes are large cells, 12-20μ in diameter, and are usually said to have kidney-shaped nuclei. The monocyte constitutes 3-7% of the leukocyte population. Some monocyte nuclei are rather round, but their chromatin is thick and stringy rather than granular as lymphocytes. Monocytes have ample cytoplasm and contain numerous granules (lysosomes) at the ultrastructural level of resolution . Monocytes are potentially foreign-body scavengers and thus their granules represent lysosomes.Top of page
Platelets
Another cellular element of the blood is the platelet. This is a membrane bound fragment of cytoplasm broken off from megakaryocyte found within the bone marrow. Platelets are very small (2-4μm and irregularly shaped). These elements tend to occur in clumps of granular, metachromatic bodies, which individually are much smaller than RBCs (A-100 [40x-labeled, 40x-labeled]). Platelets are important elements in the formation of blood clots. In electron micrographs, they are merely a bit of cytoplasm.Top of page
Blood Cells Image Gallery
Blood Cells Table of Identifications
| Row | Structure | Abbreviation | Optimal Stain | Representative Section | Note |
|---|---|---|---|---|---|
| 1 | Erythrocyte | (none) | Wright | |
|
| 2 | Platelet | (none) | Wright | |
|
| 3 | Lymphocyte | (none) | Wright | |
|
| 4 | Neutrophil ("PMN") | (none) | Wright | |
|
| 5 | Monocyte | (none) | Wright | |
|
| 6 | Eosinophil | (none), (unlabeled) | Wright | |
|
| 7 | Basophil | (unlabeled) | Wright | |
Top of page
Differential
The differential white count is used by clinicians in the diagnosing of fever and infections. They look at 100 white blood cells and classify them by type. The normal percentages are: Differential White Count| Cell Type | Normal (%) |
|---|---|
| Neutrophil | 47-77% |
| Eosinophil | 0.3-7% |
| Basophil | 0.3-2% |
| Lymphocyte | 16-43% |
| Monocyte | 0.5-10% |
Top of page
Hematopoiesis: Bone marrow
Because of artifacts in the preparations, not every cell can be unequivocally classified. You should look for characteristic examples of the various stages of erythrocytic and myeloid development, and know the patterns of blood cell formation. You should also be aware that different texts may use different names for similar stages in blood development. The examples in your own class set will have abnormal cells and many plasma cells since most of these are taken from patients with various types of blood disorders (slide A-4 - Human bone marrow, H&E [2.5x, 10x-labeled, 20x, 40x] [10x, 20x-labeled, 40x] [2.5x, 10x, 20x, 40x]; A-5 - Human bone marrow, Wright's stain with Giemsa [10x, 20x, 40x, 40x, 40x, 40x] [40x, 40x, 40x, 40x, 40x, 40x, 40x]). The red marrow of adult human bones is the major site of formation of erythrocytes, granulocytes, monocytes, and platelets. The most frequent precursor series is the erythroid cell series with the neutrophilic series being second in frequency and occurrence. You should be able to correlate and understand the events that are occurring in these cells at the molecular level with their characteristic appearances in these stained preparations. Scan the slide under low power. The most immediately obvious cell type will be the enormous megakaryocytes (this cell may be absent from some slides). The next largest cells to be seen are the stem cells. Switch to high dry or oil immersion. Use the following clues to identify the immature blood cells. Again, do not attempt to identify all the cells in the smear, but rather try to find good examples of each. Erythrocytic Series:- Proerythroblast: May be larger (20-25 μm) than stem cell. Cytoplasm basophilic. Does not possess cytoplasmic granules. Large, round nucleus occupying 80% of cell volume. Finely dispersed chromatin with little condensation or clumping.
- Basophilic Erythroblast: Smaller (12-15 μm) cell with no granules in deeply basophilic cytoplasm. With each mitotic division, basophilia of cytoplasm decreases due to presence of hemoglobin. Nucleus has coarser, darker staining chromatin than proerythroblast.
- Polychromatophilic Erythroblast: Smaller (10-12 μm) cell. Varying amounts of hemoglobin cause cytoplasm to stain a mixture of blue, violet, and gray. Nucleus has heavy, coarse, dark chromatin with a checker board appearance.
- Normoblast: Smaller cell (8-10 μm), acidophilic (pink) cytoplasm, small, shrunken, pyknotic nucleus.
- Reticulocyte (Polychromatophilic Erythrocyte): This cell may not be distinguished by the stain used for your slide. Slightly larger (10 μm) than mature RBC. Nucleus lost. Cytoplasm acidophilic or slightly basophilic. Supravital staining (e.g., Cresyl violet) demonstrates presence of cytoplasmic reticular network of cell organelle remnants, particularly ribosomes. Small numbers can be found in peripheral blood.
- Mature Erythrocytes: (7-8 μm).
- Promyelocyte: (Progranulocyte) (Large 15-18 μm), mitotic cell with nonspecific azurophilic granules in basophilic cytoplasm. Nucleus with fewer nucleoli and coarser chromatin.
- Myelocyte: Abundant (12-15%) highly mitotic, smaller cell (12-14 μm), less basophilic cytoplasm with many specific granules. Dense, large, round nucleus with noticeable indentation.
- Metamyelocyte: Not mitotic. Abundant (20%), smaller (12 μm) cell with lightly basophilic cytoplasm. Nucleus is bean shaped. Specific granules (neutro-eosinobasophilic) prominent.
- Band Cell: Not mitotic. Size: (9-12 μm). Cytoplasm filled with specific neutrophilic granules. Elongated, horseshoe-shaped nucleus. Nucleus has not become fully lobed. Neutrophilic form commonly found in peripheral blood.
- Mature Granulocytes:
- Megakaryocytes: A large cell with a conspicuous multilobed nucleus. Cytoplasm contains fine granules. Megakaryocytes by electron micrographs are distinctive due to the demarcation channels (see R-P, Fig. 10.13).
Bone Marrow Image Gallery
Bone Marrow Table of Identifications
| Row | Structure | Abbreviation | Optimal Stain | Representative Section | Note |
|---|---|---|---|---|---|
| 1 | Proerythroblast | (none) | |||
| 2 | Basophilic Erythroblast | (none) | |||
| 3 | Polychromatophilic Erythroblast | (none) | |||
| 4 | Normoblast | (none) | |||
| 5 | Reticulocyte | (none) | |||
| 6 | Mature Erythrocyte | (none) | |||
| 7 | Promyelocyte | (none) | |||
| 8 | Myelocyte | (none) | |||
| 9 | Metamyelocyte | (none) | |||
| 10 | Band Cell | (none) | |||
| 11 | Mature Granulocyte | (none) | |||
| 12 | Megakaryocyte | (none) | H&E | |
|
| 13 | Marrow Space | (none) | H&E | |
|
| 14 | Marrow Sinus | (none) | H&E | |
|
| 15 | Bone | (none) | H&E | |
Top of page
Chapter Ten Review
Review of Slides
Review of Identifications
Top of page
Comments
Top of page -- AshleyLPistorio - 27 May 2007Edit | Attach | Print version | History: r2 < r1 | Backlinks | View wiki text | More topic actions
Topic revision: r2 - 20 Jun 2015, LorenEvey
- Epithelium
- Connective Tissue
- Muscle
- Nervous Tissue
- Cardiovascular System
- Skin Appendages and Sensory Receptors
- Lymphatic System
- Cartilage and Bone
- Respiratory System
- Peripheral Blood and Bone Marrow
- Oral Cavity and Salivary Glands
- Esophagus and Gastrointestinal Tract
- Pancreas, Liver, and Gall Bladder
- Endocrine Organs
- Male Reproductive System
- Female Reproductive System
- Urinary System
 Copyright © by the contributing authors. All material on this collaboration platform is the property of the contributing authors.
Copyright © by the contributing authors. All material on this collaboration platform is the property of the contributing authors. Ideas, requests, problems regarding Medical Histology? Send feedback